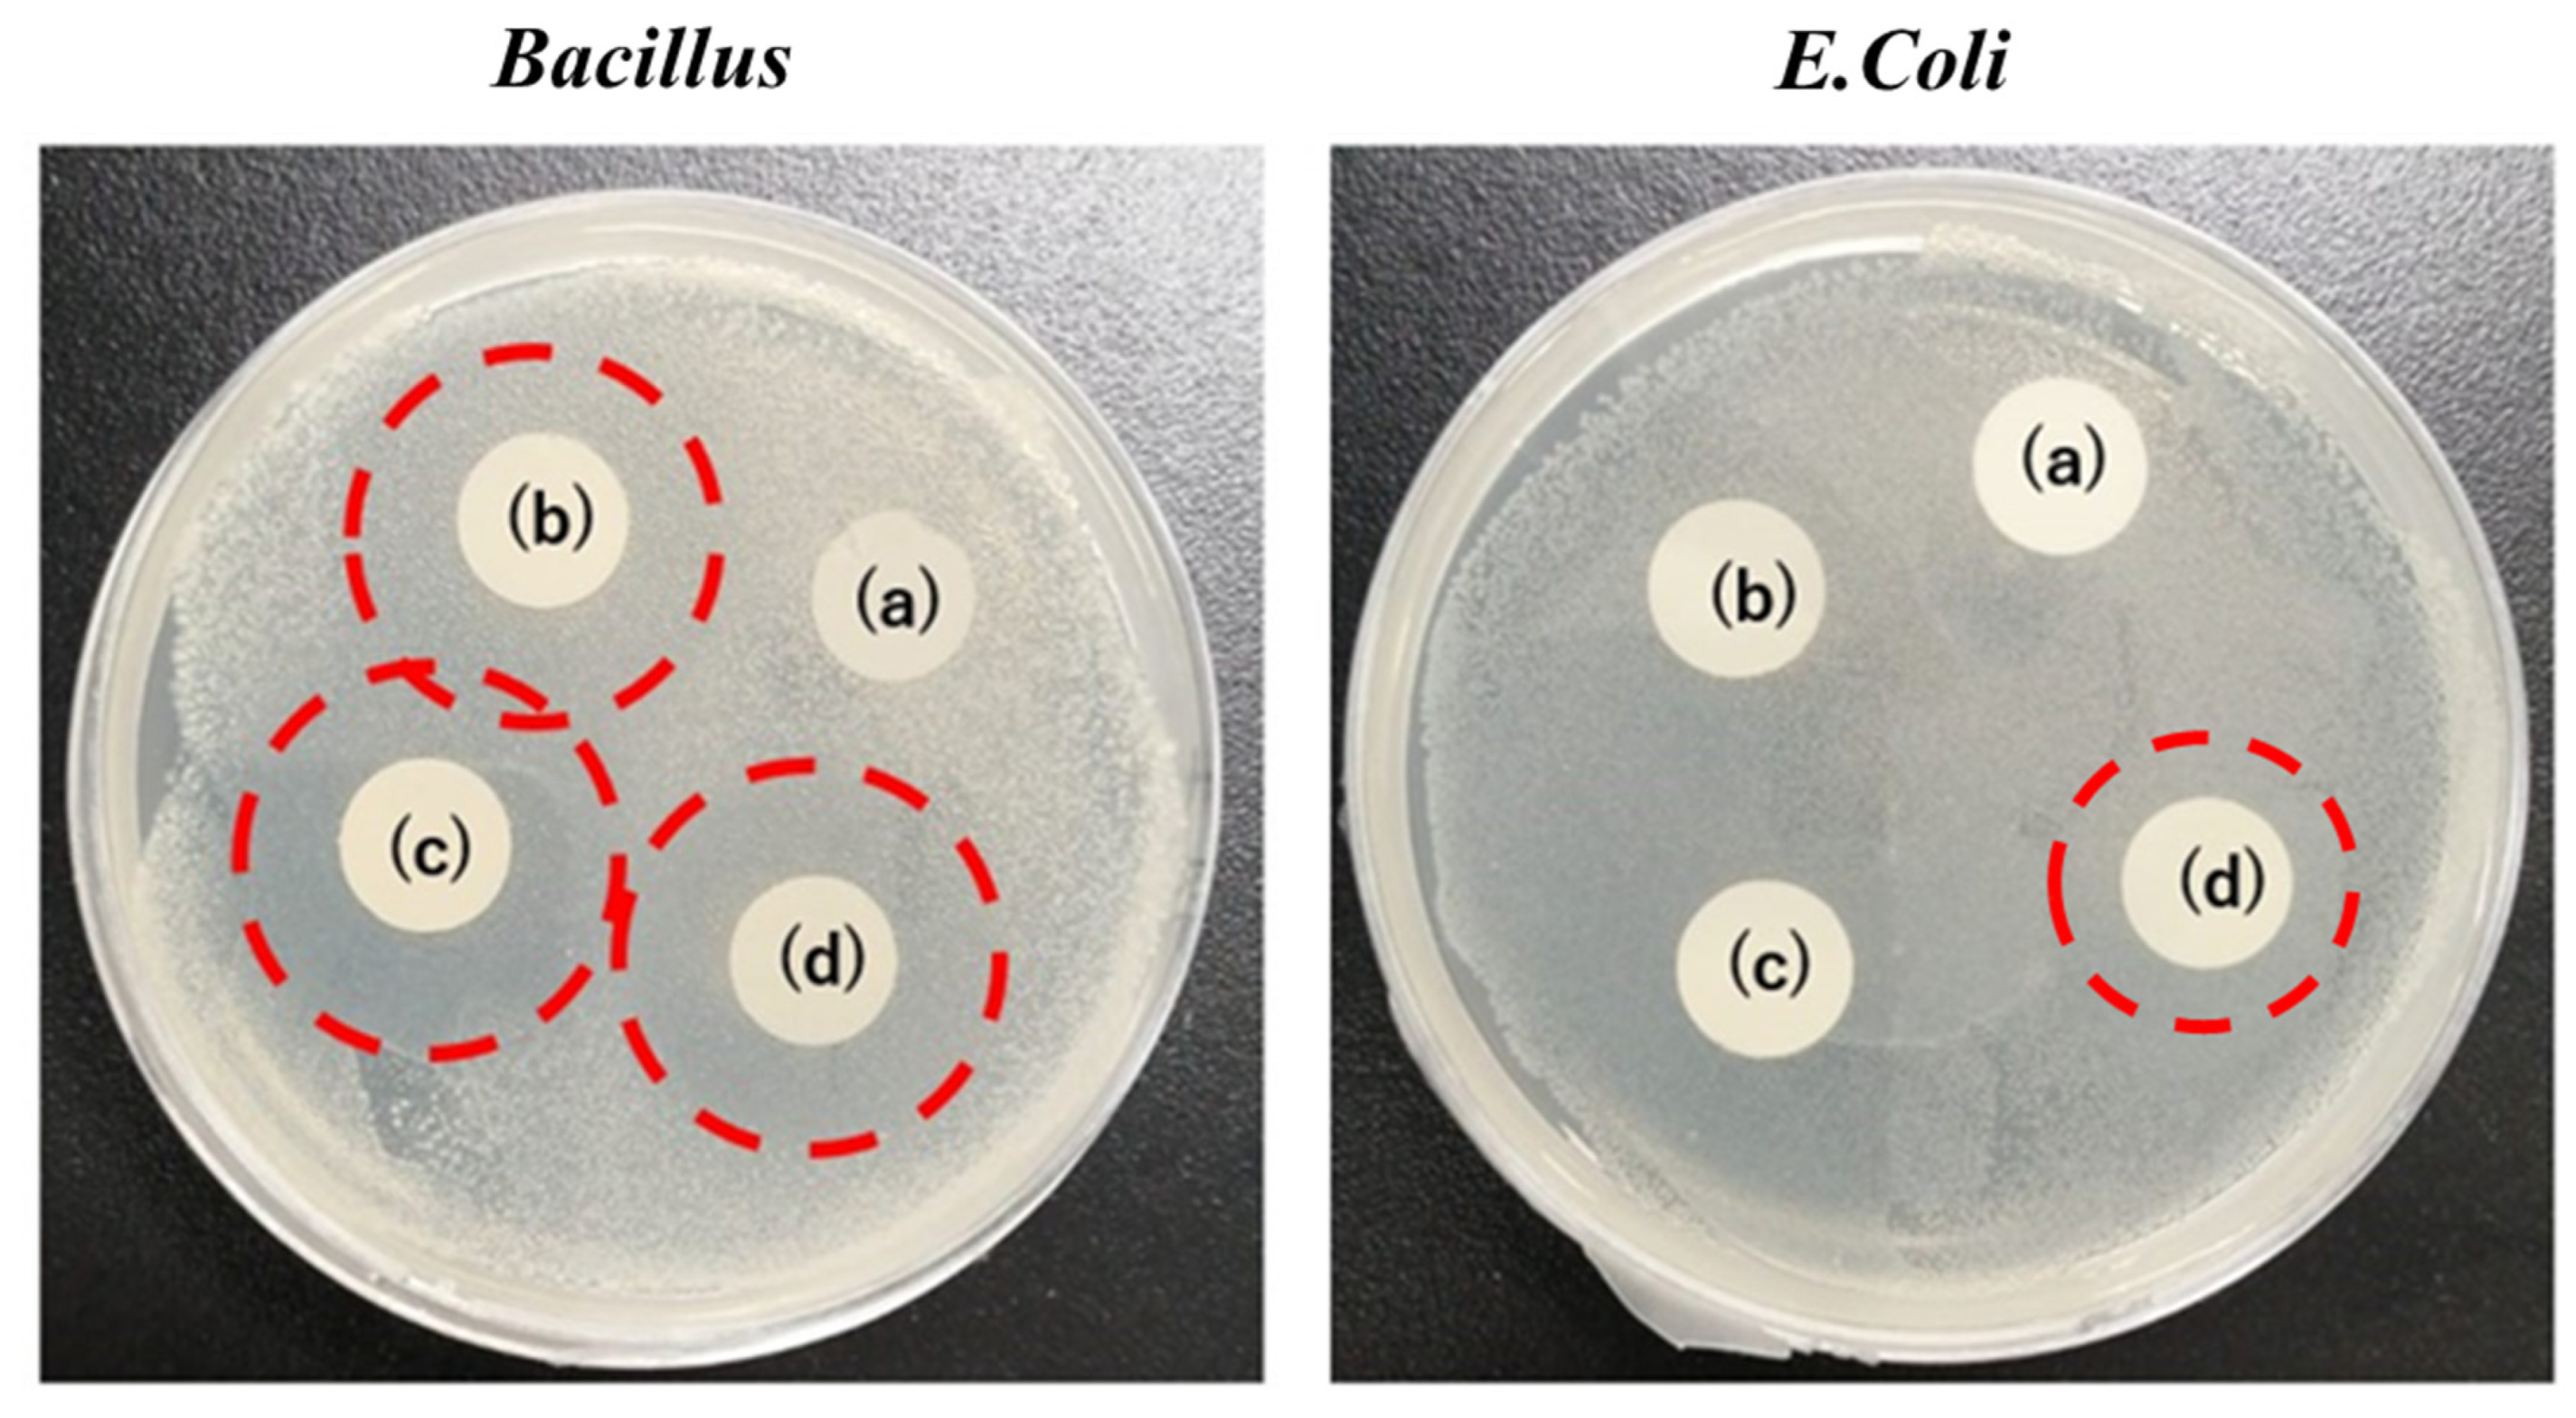
Polymers 15 02538 g008

Fabrication of Electrospun PVA/Zein/Gelatin Based Active Packaging for Quality Maintenance of Different Food Items
Abstract
1. Introduction
2. Experimental Work
2.1. Materials
2.2. Methods
3. Characterizations
4. Results and Discussions
4.1. Morphological Properties
4.2. X-ray Diffraction (XRD)
4.3. Fourier-Transform Infrared Spectroscopy (FTIR)
4.4. Antioxidant Activity
4.5. TGA Analysis
4.6. Mechanical Analysis
4.7. Water Contact Angle
4.8. Antibacterial Activity for Bacillus and E. coli Bacteria
4.9. Shelf Life Test
4.9.1. Shelf Life of Sweet Potatoes and Potatoes
4.9.2. Shelf Life of Kimchi
5. Conclusions
Author Contributions
Funding
Institutional Review Board Statement
Data Availability Statement
Conflicts of Interest
References
- Khan, M.Q.; Kharaghani, D.; Nishat, N.; Ishikawa, T.; Ullah, S.; Lee, H.; Khatri, Z.; Kim, I.S. The Development of Nanofiber Tubes Based on Nanocomposites of Polyvinylpyrrolidone Incorporated Gold Nanoparticles as Scaffolds for Neuroscience Application in Axons. Text. Res. J. 2018, 89, 004051751880118. [Google Scholar] [CrossRef]
- Ullah, S.; Ullah, A.; Lee, J.; Jeong, Y.; Hashmi, M.; Zhu, C.; Joo, K.I.; Cha, H.J.; Kim, I.S. Reusability Comparison of Melt-Blown vs Nanofiber Face Mask Filters for Use in the Coronavirus Pandemic. ACS Appl. Nano Mater. 2020, 3, 7231–7241. [Google Scholar] [CrossRef]
- Hashmi, M.; Ullah, S.; Kim, I.S. Copper Oxide (CuO) Loaded Polyacrylonitrile (PAN) Nanofiber Membranes for Antimicrobial Breath Mask Applications. Curr. Res. Biotechnol. 2019, 1, 1–10. [Google Scholar] [CrossRef]
- Kharaghani, D.; Gitigard, P.; Ohtani, H.; Kim, K.O.; Ullah, S.; Saito, Y.; Khan, M.Q.; Kim, I.S. Design and Characterization of Dual Drug Delivery Based on In-Situ Assembled PVA/PAN Core-Shell Nanofibers for Wound Dressing Application. Sci. Rep. 2019, 9, 12640. [Google Scholar] [CrossRef] [PubMed]
- Kalalinia, F.; Taherzadeh, Z.; Jirofti, N.; Amiri, N.; Foroghinia, N.; Beheshti, M.; Bazzaz, B.S.F.; Hashemi, M.; Shahroodi, A.; Pishavar, E.; et al. Evaluation of Wound Healing Efficiency of Vancomycin-Loaded Electrospun Chitosan/Poly Ethylene Oxide Nanofibers in Full Thickness Wound Model of Rat. Int. J. Biol. Macromol. 2021, 177, 100–110. [Google Scholar] [CrossRef] [PubMed]
- Motealleh, B.; Zahedi, P.; Rezaeian, I.; Moghimi, M.; Abdolghaffari, A.H.; Zarandi, M.A. Morphology, Drug Release, Antibacterial, Cell Proliferation, and Histology Studies of Chamomile-Loaded Wound Dressing Mats Based on Electrospun Nanofibrous Poly(ε-Caprolactone)/Polystyrene Blends. J. Biomed. Mater. Res. B Appl. Biomater. 2014, 102, 977–987. [Google Scholar] [CrossRef] [PubMed]
- Aruan, N.M.; Sriyanti, I.; Edikresnha, D.; Suciati, T.; Munir, M.M.; Khairurrijal, K. Polyvinyl Alcohol/Soursop Leaves Extract Composite Nanofibers Synthesized Using Electrospinning Technique and Their Potential as Antibacterial Wound Dressing. Procedia Eng. 2017, 170, 31–35. [Google Scholar] [CrossRef]
- Alipour, R.; Khorshidi, A.; Shojaei, A.F.; Mashayekhi, F.; Moghaddam, M.J.M. Silver Sulfadiazine-Loaded PVA/CMC Nanofibers for the Treatment of Wounds Caused by Excision. Fibers Polym. 2019, 20, 2461–2469. [Google Scholar] [CrossRef]
- Bie, X.; Khan, M.Q.; Ullah, A.; Ullah, S.; Kharaghani, D.; Phan, D.-N.; Tamada, Y.; Kim, I.S. Fabrication and Characterization of Wound Dressings Containing Gentamicin/Silver for Wounds in Diabetes Mellitus Patients. Mater. Res. Express 2020, 7, 045004. [Google Scholar] [CrossRef]
- Ullah, S.; Hashmi, M.; Khan, M.Q.; Kharaghani, D.; Saito, Y.; Yamamoto, T.; Kim, I.S. Silver Sulfadiazine Loaded Zein Nanofiber Mats as a Novel Wound Dressing. RSC Adv. 2019, 9, 268–277. [Google Scholar] [CrossRef]
- GhavamiNejad, A.; Rajan Unnithan, A.; Ramachandra Kurup Sasikala, A.; Samarikhalaj, M.; Thomas, R.G.; Jeong, Y.Y.; Nasseri, S.; Murugesan, P.; Wu, D.; Hee Park, C.; et al. Mussel-Inspired Electrospun Nanofibers Functionalized with Size-Controlled Silver Nanoparticles for Wound Dressing Application. ACS Appl. Mater. Interfaces 2015, 7, 12176–12183. [Google Scholar] [CrossRef]
- Ullah, S.; Hashmi, M.; Hussain, N.; Ullah, A.; Sarwar, M.N.; Saito, Y.; Kim, S.H.; Kim, I.S. Stabilized Nanofibers of Polyvinyl Alcohol (PVA) Crosslinked by Unique Method for Efficient Removal of Heavy Metal Ions. J. Water Process Eng. 2020, 33, 101111. [Google Scholar] [CrossRef]
- Fuadi, Z.; Rahmadiawan, D.; Kurniawan, R.; Mulana, F.; Abral, H.; Nasruddin, N.; Khalid, M. Effect of Graphene Nanoplatelets on Tribological Properties of Bacterial Cellulose/Polyolester Oil Bio-Lubricant. Front. Mech. Eng. 2022, 8, 810847. [Google Scholar] [CrossRef]
- Deng, L.; Li, Y.; Feng, F.; Zhang, H. Study on Wettability, Mechanical Property and Biocompatibility of Electrospun Gelatin/Zein Nanofibers Cross-Linked by Glucose. Food Hydrocoll. 2019, 87, 1–10. [Google Scholar] [CrossRef]
- Ku, K.; Song, K. Bin Physical Properties of Nisin-Incorporated Gelatin and Corn Zein Films and Antimicrobial Activity against Listeria Monocytogenes. J. Microbiol. Biotechnol. 2007, 17, 520–523. [Google Scholar]
- Ghalei, S.; Asadi, H.; Ghalei, B. Zein Nanoparticle-Embedded Electrospun PVA Nanofibers as Wound Dressing for Topical Delivery of Anti-Inflammatory Diclofenac. J. Appl. Polym. Sci. 2018, 135, 46643. [Google Scholar] [CrossRef]
- Torkamani, A.E.; Syahariza, Z.A.; Norziah, M.H.; Wan, A.K.M.; Juliano, P. Encapsulation of Polyphenolic Antioxidants Obtained from Momordica Charantia Fruit within Zein/Gelatin Shell Core Fibers via Coaxial Electrospinning. Food Biosci. 2018, 21, 60–71. [Google Scholar] [CrossRef]
- Chen, X.; Xiao, J.; Cai, J.; Liu, H. Phase Separation Behavior in Zein-Gelatin Composite Film and Its Modulation Effects on Retention and Release of Multiple Bioactive Compounds. Food Hydrocoll. 2020, 109, 106105. [Google Scholar] [CrossRef]
- Kayaci, F.; Uyar, T. Electrospun Zein Nanofibers Incorporating Cyclodextrins. Carbohydr. Polym. 2012, 90, 558–568. [Google Scholar] [CrossRef]
- Corradini, E.; Curti, P.S.; Meniqueti, A.B.; Martins, A.F.; Rubira, A.F.; Muniz, E.C. Recent Advances in Food-Packing, Pharmaceutical and Biomedical Applications of Zein and Zein-Based Materials. Int. J. Mol. Sci. 2014, 15, 22438–22470. [Google Scholar] [CrossRef]
- Ahammed, S.; Liu, F.; Khin, M.N.; Yokoyama, W.H.; Zhong, F. Improvement of the Water Resistance and Ductility of Gelatin Film by Zein. Food Hydrocoll. 2020, 105, 105804. [Google Scholar] [CrossRef]
- Deng, L.; Li, Y.; Feng, F.; Wu, D.; Zhang, H. Encapsulation of Allopurinol by Glucose Cross-Linked Gelatin/Zein Nanofibers: Characterization and Release Behavior. Food Hydrocoll. 2019, 94, 574–584. [Google Scholar] [CrossRef]
- Torres-Giner, S.; Gimenez, E.; Lagaron, J.M. Characterization of the Morphology and Thermal Properties of Zein Prolamine Nanostructures Obtained by Electrospinning. Food Hydrocoll. 2008, 22, 601–614. [Google Scholar] [CrossRef]
- Senna, M.M.; Salmieri, S.; El-Naggar, A.W.; Safrany, A.; Lacroix, M. Improving the Compatibility of Zein/Poly(Vinyl Alcohol) Blends by Gamma Irradiation and Graft Copolymerization of Acrylic Acid. J. Agric. Food Chem. 2010, 58, 4470–4476. [Google Scholar] [CrossRef]
- Zhang, M.; Liu, Y.; Yi, H.; Luan, J.; Zhang, Y.; Cai, H.; Sun, D. Electrospun Zein/PVA Fibrous Mats as Three-Dimensional Surface for Embryonic Stem Cell Culture. J. Text. Inst. 2014, 105, 246–255. [Google Scholar] [CrossRef]
- Liang, J.; Chen, R. Impact of Cross-Linking Mode on the Physical Properties of Zein/PVA Composite Films. Food Packag. Shelf Life 2018, 18, 101–106. [Google Scholar] [CrossRef]
- He, M.; Chen, M.; Dou, Y.; Ding, J.; Yue, H.; Yin, G.; Chen, X.; Cui, Y. Electrospun Silver Nanoparticles-Embedded Feather Keratin/Poly(Vinyl Alcohol)/Poly(Ethylene Oxide) Antibacterial Composite Nanofibers. Polymers 2020, 12, 305. [Google Scholar] [CrossRef]
- Rahmadiawan, D.; Abral, H.; Railis, R.M.; Iby, I.C.; Mahardika, M.; Handayani, D.; Natrana, K.D.; Juliadmi, D.; Akbar, F. The Enhanced Moisture Absorption and Tensile Strength of PVA/Uncaria Gambir Extract by Boric Acid as a Highly Moisture-Resistant, Anti-UV, and Strong Film for Food Packaging Applications. J. Compos. Sci. 2022, 6, 337. [Google Scholar] [CrossRef]
- Rahmadiawan, D.; Abral, H.; Yesa, W.H.; Handayani, D.; Sandrawati, N.; Sugiarti, E.; Muslimin, A.N.; Sapuan, S.M.; Ilyas, R.A. White Ginger Nanocellulose as Effective Reinforcement and Antimicrobial Polyvinyl Alcohol/ZnO Hybrid Biocomposite Films Additive for Food Packaging Applications. J. Compos. Sci. 2022, 6, 316. [Google Scholar] [CrossRef]
- Xia, C.; Wang, W.; Wang, L.; Liu, H.; Xiao, J. Multilayer Zein/Gelatin Films with Tunable Water Barrier Property and Prolonged Antioxidant Activity. Food Packag. Shelf Life 2019, 19, 76–85. [Google Scholar] [CrossRef]
- Liu, Y.; Geever, L.M.; Kennedy, J.E.; Higginbotham, C.L.; Cahill, P.A.; McGuinness, G.B. Thermal Behavior and Mechanical Properties of Physically Crosslinked PVA/Gelatin Hydrogels. J. Mech. Behav. Biomed Mater. 2010, 3, 203–209. [Google Scholar] [CrossRef] [PubMed]
- Tareq, A.; Hussein, M.; Mustafa, A. Synthesis and Characterization of PVA-Gelatin Hydrogel Membranes for Controlled Delivery of Captopril. Int. Res. J. Pure Appl. Chem. 2016, 12, 1–10. [Google Scholar] [CrossRef]
- Charron, P.N.; Braddish, T.A.; Floreani, R. PVA-Gelatin Hydrogels Formed Using Combined Theta-Gel and Cryo-Gel Fabrication Techniques. J. Mech. Behav. Biomed. Mater. 2017, 176, 139–148. [Google Scholar] [CrossRef]
- Fan, H.Y.; Duquette, D.; Dumont, M.J.; Simpson, B.K. Salmon Skin Gelatin-Corn Zein Composite Films Produced via Crosslinking with Glutaraldehyde: Optimization Using Response Surface Methodology and Characterization. Int. J. Biol. Macromol. 2018, 120, 263–273. [Google Scholar] [CrossRef] [PubMed]
- Rodríguez-Rodríguez, R.; García-Carvajal, Z.Y.; Jiménez-Palomar, I.; Jiménez-Avalos, J.A.; Espinosa-Andrews, H. Development of Gelatin/Chitosan/PVA Hydrogels: Thermal Stability, Water State, Viscoelasticity, and Cytotoxicity Assays. J. Appl. Polym. Sci. 2019, 136, 47149. [Google Scholar] [CrossRef]
- Thangprasert, A.; Tansakul, C.; Thuaksubun, N.; Meesane, J. Mimicked Hybrid Hydrogel Based on Gelatin/PVA for Tissue Engineering in Subchondral Bone Interface for Osteoarthritis Surgery. Mater. Des. 2019, 183, 108113. [Google Scholar] [CrossRef]
- Imtiaz, N.; Niazi, M.B.K.; Fasim, F.; Khan, B.A.; Bano, S.A.; Shah, G.M.; Badshah, M.; Menaa, F.; Uzair, B. Fabrication of an Original Transparent PVA/Gelatin Hydrogel: In Vitro Antimicrobial Activity against Skin Pathogens. Int. J. Polym. Sci. 2019, 2019, 7651810. [Google Scholar] [CrossRef]
- Ge, Y.; Tang, J.; Ullah, A.; Ullah, S.; Sarwar, M.N.; Kim, I.S. Sabina Chinensis Leaf Extracted and in Situ Incorporated Polycaprolactone/Polyvinylpyrrolidone Electrospun Microfibers for Antibacterial Application. RSC Adv. 2021, 11, 18231–18240. [Google Scholar] [CrossRef]
- Sarwar, M.N.; Ullah, A.; Haider, M.K.; Hussain, N.; Ullah, S.; Hashmi, M.; Khan, M.Q.; Kim, I.S. Evaluating Antibacterial Efficacy and Biocompatibility of PAN Nanofibers Loaded with Diclofenac Sodium Salt. Polymers 2021, 13, 510. [Google Scholar] [CrossRef]

Disclaimer/Publisher’s Note: The statements, opinions and data contained in all publications are solely those of the individual author(s) and contributor(s) and not of MDPI and/or the editor(s). MDPI and/or the editor(s) disclaim responsibility for any injury to people or property resulting from any ideas, methods, instructions or products referred to in the content. |
© 2023 by the authors. Licensee MDPI, Basel, Switzerland. This article is an open access article distributed under the terms and conditions of the Creative Commons Attribution (CC BY) license (https://creativecommons.org/licenses/by/4.0/).
Share and Cite
Ullah, S.; Hashmi, M.; Shi, J.; Kim, I.S. Fabrication of Electrospun PVA/Zein/Gelatin Based Active Packaging for Quality Maintenance of Different Food Items. Polymers 2023, 15, 2538. https://doi.org/10.3390/polym15112538
Ullah S, Hashmi M, Shi J, Kim IS. Fabrication of Electrospun PVA/Zein/Gelatin Based Active Packaging for Quality Maintenance of Different Food Items. Polymers. 2023; 15(11):2538. https://doi.org/10.3390/polym15112538
Chicago/Turabian StyleUllah, Sana, Motahira Hashmi, Jian Shi, and Ick Soo Kim. 2023. "Fabrication of Electrospun PVA/Zein/Gelatin Based Active Packaging for Quality Maintenance of Different Food Items" Polymers 15, no. 11: 2538. https://doi.org/10.3390/polym15112538
APA StyleUllah, S., Hashmi, M., Shi, J., & Kim, I. S. (2023). Fabrication of Electrospun PVA/Zein/Gelatin Based Active Packaging for Quality Maintenance of Different Food Items. Polymers, 15(11), 2538. https://doi.org/10.3390/polym15112538

